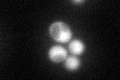
YHR137W
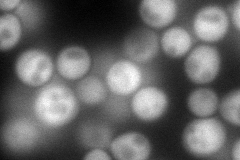
YHR137W
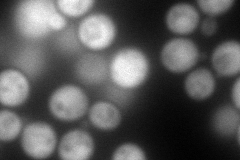
YHR137W
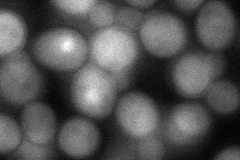
YHR137W
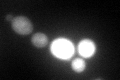
YHR137W

View description
Aromatic aminotransferase II, catalyzes the first step of tryptophan, phenylalanine, and tyrosine catabolism
Localization:
Intensity:
Fold change:
Significance:
-
C’ GFP library in SD
cytosol102.01 -
N' NOP1pr-GFP in SD
cytosol157.958 -
N' TEF2pr-mCherry in SD
cytosol239.084 -
N' NATIVEpr-GFP in SD

cytosol30.6885 -
N' TEF2pr-VC and Cyto-VN in SD
cytosol76.9341 -
C’ GFP library in SD+DTT
cytosol58.050.56Yes -
C’ GFP library in SD+H2O2

cytosol111.551.09No -
C’ GFP library in Starvation Media

cytosol15.560.15No -
C’ GFP library on the background of Pup2-DaMP

cytosol -
C’ GFP library on the background of CCT mutant

cytosol91.11160.893099No
